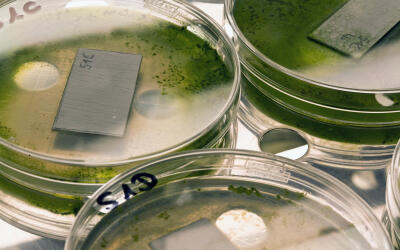
Virkon S – эффективное средство биологической защиты от африканской чумы свиней

Главные новости
-
Virkon S – эффективное средство биологической защиты от африканской чумы свиней
02.02.18 в 14:52
Virkon S – эффективное средство биологической защиты от африканской чумы свиней
02.02.18 в 14:52LANXESS готов предоставить свиноводческим хозяйствам дезинфицирующий препарат с доказанной эффективностью для предупреждения распространения и ликвидации вируса африканской чумы свиней.
-
 Дмитрий Потапенко выступит в качестве экспертного спикера на форуме "Точка роста" в рамках VI Международного аграрного форума "АгроЭкспоКрым"
02.02.18 в 14:16
Дмитрий Потапенко выступит в качестве экспертного спикера на форуме "Точка роста" в рамках VI Международного аграрного форума "АгроЭкспоКрым"
02.02.18 в 14:1615 февраля в Ялте, в рамках VI Международного аграрного форума "АгроЭкспоКрым" состоится форум «Точка роста».
-
 «Объективно лучше!» - «АгроТехХолдинг» на АГРОСАЛОН
01.02.18 в 14:07
«Объективно лучше!» - «АгроТехХолдинг» на АГРОСАЛОН
01.02.18 в 14:07Воронежская компания «АгроТехХолдинг» приняло решение вновь участвовать в крупнейшей в России выставке сельхозтехники АГРОСАЛОН, которая пройдет осенью в Москве.
-
Российские семеноводы закладывают основу будущих рекордных урожаев
01.02.18 в 13:0830 января первый заместитель министра сельского хозяйства Джамбулат Хатуов принял участие во Всероссийском ежегодном совещании с руководителями филиалов ФГБУ «Госсорткомиссия».
-
 Новый проект «Черкизово» – «Моссельпром+»
01.02.18 в 12:11
Новый проект «Черкизово» – «Моссельпром+»
01.02.18 в 12:11Группа «Черкизово», лидер мясной индустрии России, ориентированный на производство высококачественной продукции для потребителей, завершает реализацию первой стадии проекта по расширению мощностей птицефабрики «Моссельпром».
-
 Минсельхоз расширил доктрину продовольственной безопасности России
31.01.18 в 09:07
Минсельхоз расширил доктрину продовольственной безопасности России
31.01.18 в 09:07В России появится минимальная норма обеспеченности фруктами, ягодами и овощами. Показатели по этим продуктам Минсельхоз включил в обновленную версию Доктрины продовольственной безопасности.
-
Аграрии СНГ обсудили направления сотрудничества в семеноводстве
30.01.18 в 15:3625-26 января в Самарканде (Республика Узбекистан) прошло заседание Межправительственного координационного совета по вопросам семеноводства СНГ.
-
 На сегодняшний день состояние озимых удовлетворительно
30.01.18 в 15:30
На сегодняшний день состояние озимых удовлетворительно
30.01.18 в 15:30Минсельхозом проводится постоянный мониторинг состояния озимых посевов. На конец января 2018 года, состояние озимых зерновых культур в России на 95% посевных площадей оценивается как хорошее и удовлетворительное.
-
 Осенью 2018 года в Москве пройдет выставка АГРОСАЛОН
29.01.18 в 14:53
Осенью 2018 года в Москве пройдет выставка АГРОСАЛОН
29.01.18 в 14:53В начале октября в Москве, в МВЦ «Крокус Экспо» пройдет международная специализированная выставка сельхозтехники АГРОСАЛОН - результат работы отраслевых ассоциаций производителей сельхозтехники «Росспецмаш» и германской «VDMA Landtecknik».
-
 Новые требования к производству масложировой продукции
29.01.18 в 13:35
Новые требования к производству масложировой продукции
29.01.18 в 13:35С 1 января 2018 года вступили в силу обязательные требования к масложировой продукции, установленные техническим регламентом Таможенного союза «Технический регламент на масложировую продукцию» (ТР ТС 024/2011). Они изменяют показатель безопасности «транс-изомеры жирных кислот» с 20 до 2% от содержания жира в продукте.
-
 Представляем программу и участников IX Международной аграрной конференции ГДЕ МАРЖА 2018
26.01.18 в 13:26
Представляем программу и участников IX Международной аграрной конференции ГДЕ МАРЖА 2018
26.01.18 в 13:26Подходит к завершению успешная подготовка Конференции. На сайте можно ознакомиться с предварительной Программой, спикерами и участниками.
-
 Форум инновационных аграрных технологий
26.01.18 в 10:15
Форум инновационных аграрных технологий
26.01.18 в 10:1516 февраля в рамках VI Международного Аграрного форума состоится Форум инновационных аграрных технологий при участии профессорско-преподавательского состава Академии биоресурсов и природопользования ФГАОУ ВО «Крымский федеральный университет им. В.И. Вернадского».
-
 «Агросила-Молоко» начнет выпускать продукцию стандарта «Халяль»
25.01.18 в 13:52
«Агросила-Молоко» начнет выпускать продукцию стандарта «Халяль»
25.01.18 в 13:52Произведенное по мусульманским канонам молоко появится на прилавках под брендом «Просто молоко» в марте 2018 года.
-
 На мясокомбинат «Титан-Агро» прибыло новое оборудование
25.01.18 в 12:16
На мясокомбинат «Титан-Агро» прибыло новое оборудование
25.01.18 в 12:16На мясокомбинате «Пушкинский» (ОП ООО «Титан-Агро») в феврале введут в эксплуатацию вакуум-упаковочный аппарат.
-
 Успешный опыт эксплуатации климатических систем компании «Интерагро» в России
25.01.18 в 11:25
Успешный опыт эксплуатации климатических систем компании «Интерагро» в России
25.01.18 в 11:25Компания «Интерагро», начавшая внедрение европейских технологий для качественного хранения овощей в 2009 году, доказала эффективность примененных технологий и намерена распространять географию проектов по всей территории России.
